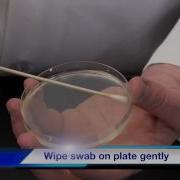

Подборки
Смотреть все
Сейчас слушают
Cengiz Coçkuner Ful Albumu
Incelikler Yuzunden
Песня Ой При Лужке При Лужке
Let You Go Alex Martura Walwin
Xassa Bodiev Самолёт Krital Adhikari Remix 2023 Krimix Car Video Mercedes G63 Amg
Той Әндері
Ofenbach Be Mine Extended Mix
Игрушки Сняли Ёлку Вынесли
Бирюзовые Глаза Валерий Курас
Chashkakefira Dj Pxrple Collar
Когда У Тебя Красивое Сердце
Сухроб Отаев Мусофир
Ты Похож На Кота Хочу Забрать Тебя Домой В Моих Глазах Горит Квазар
Аудиокнига Попаданцы Приказ Уничтожить
Для Спорта Мотивация
Bodysnatcher Dead Rabbit
Самый Лучший Сборник Песен В Машину
Спасибо Мой Родной Зато
Нет Ничто Не Вечно Под Луной
Minecraft But It S Vcjd Parts 1 4 Full Album Zenyx
Dhx Media Slow
Devblog 196
Николай Гнатюк Зорька Алая
Жаны 2018 Аваз Акимов Бир Бетин Опсом Бир Бетин Калат
Обосрался Пидорас Звук
Радио Тапок Between Angels
А Твоя Любовь Цветок Раскрылась Словно Лилия
Johnny Utah Honeypie
Говорящий Зомби В Stalker Зов Прияпяти
Kirkiimad Nowkie Нанана
Я Ждала Афина
Rasa Пчеловод Соник
Смотреть все